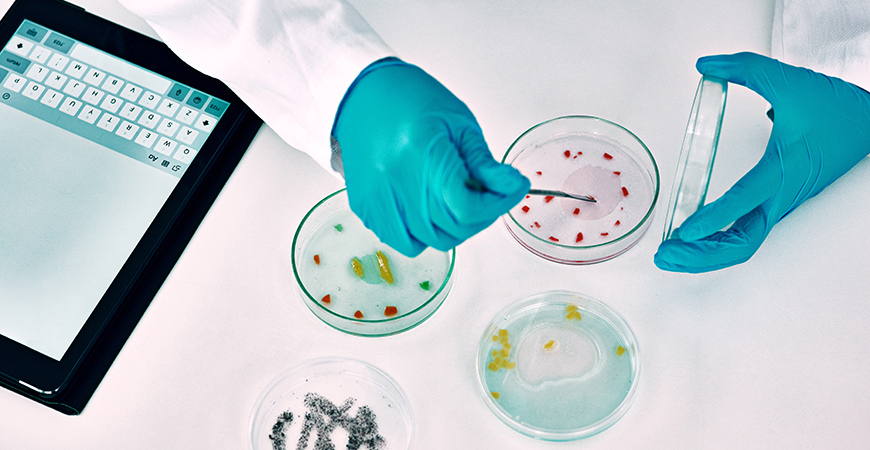
Microbiological Analysis

Food & Feed Hygiene Verification
Our microbiological testing ensures compliance with hygiene regulations for food and feed products. Through comprehensive laboratory analysis, we help you verify the microbiological safety and quality of your commodities, protecting your business from contamination-related claims and regulatory non-compliance.
With accredited testing methods and experienced laboratory professionals, our microbiological analysis services provide reliable results that meet international food safety standards and destination country requirements.
Screening Includes
- Total plate counts
- Yeast and mold enumeration
- Pathogenic bacteria testing where required
- Storage contamination assessments
Application Areas
Our microbiological testing services cover a wide range of agricultural and food commodities, ensuring hygiene compliance across diverse product categories.
- Pulses, cereals and processed feed materials
- Oilcakes and meals
- Packaged consumer food ingredients
Your Benefit
Our comprehensive microbiological analysis delivers critical benefits that protect product integrity and ensure regulatory compliance across global markets.
Hygiene Compliance
Verification
Ensure your food and feed products meet international hygiene standards and destination country microbiological limits.
Contamination Risk
Prevention
Identify microbiological contamination before shipment, preventing costly rejections, recalls and claims from buyers.
Storage Quality Assurance
Monitor storage conditions and detect contamination issues that may develop during warehousing or transit.
Frequently asked questions
Microbiological analysis tests for the presence and levels of microorganisms in food and feed products, including bacteria, yeasts, molds, and pathogens. These tests help verify hygiene standards, detect contamination, and ensure products are safe for consumption or further processing according to international food safety regulations.
Total plate count (TPC) measures the overall number of viable aerobic microorganisms in a sample. It provides a general indicator of product hygiene and can reveal contamination during processing, handling, or storage. High TPC levels may indicate poor hygiene practices or improper storage conditions.
Yeast and mold testing is essential because these organisms can cause spoilage, off-flavors, and texture changes in food products. Some molds also produce mycotoxins that pose health risks. Testing helps identify contamination issues before products reach consumers and supports compliance with quality specifications and regulatory limits.
Depending on the product type and destination requirements, we test for various pathogenic bacteria including Salmonella, E. coli, Listeria monocytogenes, and other specific pathogens. Testing protocols are tailored to product category, regulatory requirements, and buyer specifications to ensure comprehensive food safety verification.
Poor storage conditions�including high humidity, improper temperature, and extended storage periods�can promote microbial growth and contamination. Our storage contamination assessments help identify issues that may have developed during warehousing, supporting proper stock management and preventing quality degradation.
We provide microbiological testing for a wide range of agricultural and food products, including pulses, cereals, processed feed materials, oilcakes and meals, and packaged consumer food ingredients. Our testing services support both bulk commodity traders and food ingredient suppliers with hygiene verification needs.
Related Services






